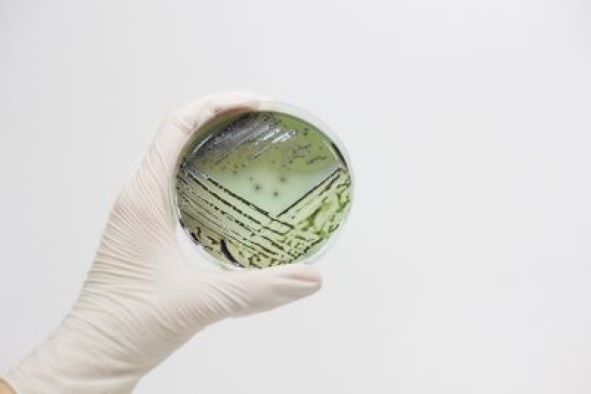
photo 2024-06-24 18-08-20

Тендітна та рішуча Українець |
|
Те, чого немає в магазині
Підприємства змінюють прописку або розширяються не лише тому, що ростуть амбіції, або вони хочуть більше заробляти. Інколи драйвером розвитку стають навіть самі мінливі та драматичні обставини. Саме це сталося з підприємством із Харкова. Розповідь почнемо з 2016 року. Саме тоді розпочало свою діяльність підприємство «САНІМЕД-М». Спочатку як офіційний представник румунської компанії на українському ринку медичних продуктів. Спеціалізація підприємства була дуже вузькою – постачання в Україну сухих та готових до споживання живильних середовищ для мікроорганізмів. Що це таке? Спробуємо пояснити. З того часу, як були відкриті мікроорганізми, мікробіологи протягом багатьох десятиліть вчилися вирощувати їх у лабораторних умовах. Це надзвичайно важливо, адже недостатньо лише побачити бактерії під мікроскопом, необхідно також вивчити їхній спосіб життя та, за необхідності, знайти методи боротьби з ними. Вивчати бактерії простіше, коли дослідник має колонію, а вона може вирости лише у комфортних умовах. Саме такий «комфорт» і забезпечують готові поживні середовища. Використовуються субстракти для аналізів не тільки для виявлення збудників різних бактеріальних інфекцій: холери, дифтерії, правця, скарлатини та інших хвороб з бактеріальними збудниками. Замовників поживних речовин багато – це лікарні, санітарні станції, лабораторії харчової промисловості, наукові інститути, дослідники довкілля. Але виробника поживних речовин в Україні не було, продукт купували у Європі та у РФ. У 2019 році компанія «САНІМЕД-М» відкрила у Харкові перший в Україні завод з виробництва готових поживних середовищ. Підприємство розширювалося, з'являлися нові клієнти в Україні й за кордоном. Чимала заслуга в тому була героїні цього матеріалу - підприємиці Олександри Українець.
Чи любите бактерій так, як люблю їх я?
«Взагалі я маю дві вищі освіти – юридичну та економічну. Була фінансовою директоркою компанії, яка продавала запасні частини для літаків, - розповідає Олександра Українець. - Потім власники компанії запропонували мені змінити напрямок роботи. Це було дуже ризикованим рішенням, але я жодного разу не пожалкувала. Звичайно довелося багато вчитися, та нова інформація засвоювалася дуже швидко, просто тому, що я чітко знала, що мені потрібно, і чого я хочу досягти». Олександра каже, що завжди мріяла займатися виробництвом, створювати продукт, який буде допомагати людям і природі. Зірки зійшлися і молода жінка поринула в роботу. Спочатку було доволі важко: про підприємство в Україні мало хто знав, поживні середовища купували переважно за кордоном, значно переплачуючи. Та з часом ситуація змінювалась. «Я йшла до клієнтів, показувала, які бактеріальні тест-системи ми виготовляємо, що вони нічим не поступаються імпортним в якості. І при цьому дешевші», - каже Олександра і зазначає, що в деяких випадках досить складним було спілкування з керівниками-чоловіками. Сприймати молоду тендітну жінку як серйозного ділового партнера їм спочатку було важко. Щоб подолати такі гендерні стереотипи, Олександра обрала стратегію професійної впевненості: вона завжди приходила на зустрічі максимально підготовленою, демонструвала глибоке знання продукту й ринку, наводила конкретні цифри та приклади успішних кейсів. Вона також налагоджувала особисту довіру, показуючи, що за її рішучістю стоїть не лише амбіція, а й реальний досвід та командна робота. З часом навіть найскептичніші партнери починали бачити в ній не «молоду жінку», а рівноправного гравця бізнесу. «САНІМЕД-М» набирав обертів. Для розвитку Олександра Українець почала активно залучати грантові кошти. Саме вона першою в Україні отримала від міжнародних донорів 300 тисяч гривень як жінка-підприємець. На підприємстві в Харкові працювало близько тридцяти унікальних фахівців, бо особисто для цього специфічного виробництва не готують в жодному навчальному закладі. «Ми єдині в Україні – це одночасно і гордість, і відсутність готових спеціалістів. Щоб стати частиною команди бажано мати освіту хіміка або біолога, добре розумітися на технологічному процесі, знати англійську і… любити бактерій. Головний критерій, за яким ми наймали людей – це мотивованість на досягнення мети та бажання працювати та навчатися. Ми дуже цінуємо своїх спеціалістів. Якийсь час через обстріли виробництво в Харкові зупинилося, але заробітну плату люди отримували».
Конструктивна стійкість
Повномасштабна війна поставила підприємство на тимчасову паузу. Чітко визначилися два пріоритети: безпека працівників та збереження бізнесу. Постійні ворожі обстріли Харкова вимусили Олександру Українець перейти в режим антикризового управління та прийняти рішення про релокацію підприємства. Вибір зупинився на Хмельницькому. Саме там і було відкрито філію «САНІМЕД-М». «Переїзд підприємства – це завжди великі незаплановані трати. Ми орендували комунальну будівлю площею 370 квадратних метрів. Приміщення було у жахливому стані, та це нам цілком підходило, бо ремонт все одно прийшлося робити – виробництво потребує дотримання відповідних санітарних вимог, – розповідає Олександра. – Замінили дах і всі комунікації: водо- і енергопостачання, опалення. Ремонтували швидко, бо, по-перше, нам потрібно було встояти на ринку; по-друге, війна значно підвищила попит на наші поживні середовища. До лікарень та баклабораторій додалися станції переливання крові та військові шпиталі. Нам постійно телефонували наші клієнти: «Запаси закінчуються. Працюйте!». У Хмельницький спочатку вивезли з Харкова лише склад готової продукції. Перевозити дороге виробниче обладнання було неможливо – потенційна шкода від демонтажу вимірювалася мільйонами гривень. Треба було купувати нове. І знову на допомогу прийшли міжнародні донори. На придбання обладнання Олександра Українець отримала грант на 100 тисяч доларів. З часом запустили виробництво і в Харкові. Зараз на ньому працюють 20 працівників. Взагалі від початку війни підприємство не тільки не припинило сою діяльність, а змогло підвищити об'єми продажів, розширити асортимент. При цьому «САНІМЕД-М» дотримується своєї основної переваги – конкурентної ціни. Вартість українських тест-систем майже вдвічі дешевша за європейські.
Забігаючи вперед
«Ми працюємо, використовуючи всі наявні можливості. Постійно навчаємося, контактуємо з іноземними партнерами, розширюємо асортимент. Кожен член нашої команди готовий робити все, що від нього залежить. Я як керівниця дуже ціную довіру людей і намагаюся робити все, щоб вони були зацікавлені працювати на підприємстві. Колись я хотіла отримувати від роботи задоволення. Тепер вона приносить ще й дохід. Моя справа - це мій обов'язок, частина життя. Саме так я завжди бачила свою професійну реалізацію», - каже Олександра Українець. Втім, у неї ще є мрія – створити спортивну легкоатлетичну школу для дітей, де будуть усі умови для занять: світле просторе приміщення та сучасне обладнання. Олександра зізнається, що ці плани були в неї завжди. Жінка активно займається легкою атлетикою – навіть приймає участь у марафонах. «Сподіваюсь, що колись втілю свій задум. Але треба враховувати цілу низку нюансів. У будь-якій справі потрібен системний підхід, та головне – мотивація, віра в себе і сильне бажання втілити свої мрії».
Дивні картини у чашці Петрі
І на останок після корисного - трохи цікавого. Для Олександри Українець мікробіологія – це не тільки наука і бізнес, а ще й простір для творчості, бо виявляється бактеріями можна малювати!
«Ти береш порожню чашку Петрі, робиш кілька мазків, і вже наступного дня бачиш, як там починає вирувати життя», - розповідає жінка. Виявляється, що намалювати бактеріями можна будь-що: орнамент, квіти, пейзаж. Щоправда, результат залежить не тільки від знань і таланту творця композиції, але й від поведінки самих бактерій. Окремі види мікроорганізмів мають свій колір та потребують різних поживних речовин. Найкращою «фарбою» Олександра вважає сальмонелу, яка дає неперевершений фіолетовий відтінок. Проте, малювати нею можна лише влітку - ця бактерія, як відомо, дуже любить тепло, водойми, пляжі та немиті руки. Кишкова паличка «цвіте» рожевим, кандида – сніжно-білим… Звісно, ніхто не працює з мікроорганізмами, які здатні викликати смертельні хвороби. Загальний принцип такої творчості можна сформулювати так: вона має бути безпечною. Але й робота із сальмонелою - це теж не іграшки, тому такі картини довго не живуть, а творчість, так би мовити, не виходить за межі лабораторії. Після нетривалого милування бактерії знищують, а згадки про красу залишаються лише на фото. Олександру Українець короткий термін життя «картин» не засмучує. Вона вважає, що вони дозволяють зовсім по-іншому подивитися на бактерій, побачити в них не тільки збудників хвороб, а частину невідомого та прекрасного мікровсесвіту.
Цей матеріал з'явився як натхнення після тренінгу "Розширенння прав і можливостей жінок-журналісток з України", що його втілюють "Гендер Зед" та "Прес-клуб реформ".
|
||
| ||
Найбільш читане
- Через російські обстріли у Краматорському районі двоє людей загинуло, п’ятеро - зазнало поранень
- Одну людину поранено вранці у краматорському селищі - попередня доба минула без постраждалих
- Попередньо – без постраждалих: ворог обстріляв 7 населених пунктів Краматорського району
- У Краматорському районі на російсько-українській війні загинув одинадцятий італієць
- Дев’ятеро поранених цивільних, серед яких неповнолітня – наслідки ворожого удару по місту в Краматорському районі (ФОТО)
Останні народні новини
- Три з трьох! Три смаки Sticketti від КИЇВХЛІБ отримали золото Favorite Food&Drinks 2026
- Ріст тарифів необхідно зупинити
- ALVIVA GROUP на Gulfood 2026: курс на підкорення ринку MENA
- ALVIVA GROUP збільшує площу посівних земель на 26% завдяки розмінуванню та рекультивації
- КИЇВХЛІБ – володар першої "Срібної кнопки" YouTube в українському фуд-сегменті
Даючи рекламу одночасно у дві газети - "Технополіс" и "Четвер", Ви заощаджуєте гроші, а реклама працює вдвічі ефективніше! Телефони відділу реклами:
(06264) 3-43-68
(06264) 3-57-44
050-855-05-12
Найкоментованіше
Опитування
Результати: 70
Ця історія про незламність, віру в себе, відкритість до нового, про вірних друзів та партнерів, а ще про можливості, яких насправді дуже багато.